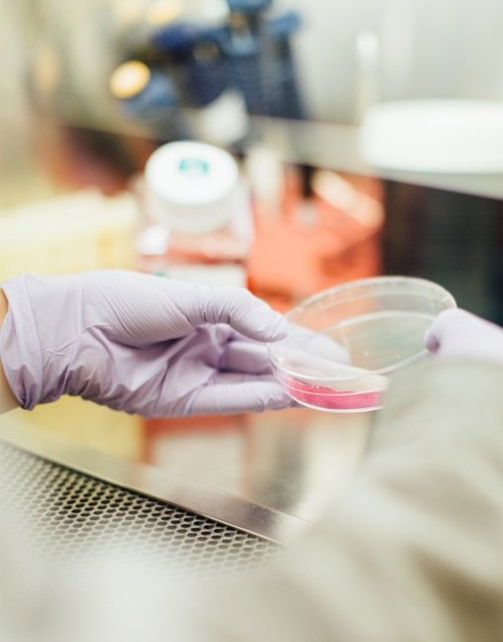

About
Pretium non tincidunt nec tempor libero sit enim nam
Donec suscipit ante ipsum. Donec convallis quam at tortor hendrerit, ut elementum augue suscipit. Morbi tincidunt risus vel neque convallis pretium non nec justo.
Aenean feugiat vulputate magna a auctor. In erat tortor, rutrum eu volutpat quis, consectetur quis enim.
Aenean feugiat vulputate magna a auctor. In erat tortor, rutrum eu volutpat quis, consectetur quis enim.
Aliquam aliquet maximus
Donec suscipit ante ipsum. Donec convallis quam at tortor hendrerit, ut elementum augue suscipit. Morbi tincidunt risus vel neque convallis pretium non nec justo. Aenean feugiat vulputate magna a auctor.


Morbi pharetra urna eget diam viverra
Donec suscipit ante ipsum. Donec convallis quam at tortor hendrerit, ut elementum augue suscipit. Morbi tincidunt risus vel neque convallis justo. Aenean feugiat vulputate magna a auctor. In erat tortor, rutrum eu volutpat quis, consectetur quis enim.
Maecenas enim sit tincidunt lacus
E-mail de contato: contato@robertomedina.com.br
© All Rights Reserved 2022
